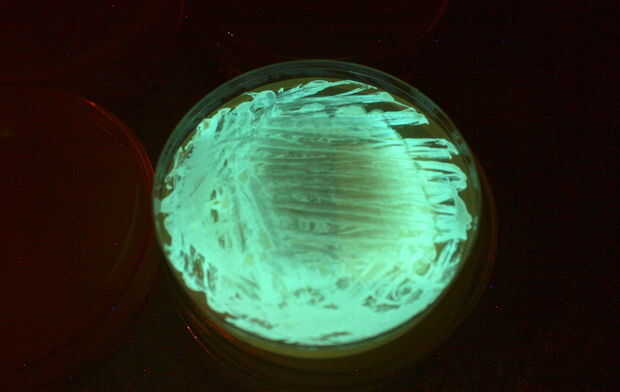

Este instructable le mostrará cómo crecer y cultura su propio brillante bacterias y usarla para reinventar la bombilla!
I "ll mostrará cómo cultivar tu propio Vibrio phosphoreum o Vibrio fischeri de pescado fresco del mar (calamar funcionan bien) y de la cultura en gel de agar especial que usted puede hacer en casa o simplemente comprar listo para verter. El gel puede ser formado dentro de todas las clases de cosas que quieres hacer un color verdoso/azul fresco resplandor!!!
Las bacterias vibrio que brillan intensamente son las formas de vida marina que viven solos o en una relación simbiótica con pescado y calamares dentro de sus órganos ligeros o como parastites. Solo las bacterias realmente no brillan pero en grupos de número bastante grande de algo increíble sucede llamado quórum sensing... Las bacterias al darse cuenta de lo suficiente entre sí alrededor de vuelta tienen genes que les permiten a GLOW!!!!!! La luz que se emite es super eficiente alrededor 98% lo que significa que sólo el 2% se pierde por calor, por lo tanto la luz es fría y que está muy chulo.
Aquí hay buena información en v. fischeri
http://www.Bionity.com/en/Encyclopedia/Vibrio_fischeri.html
Es estos increíbles a chicos pequeños (1/1.000.000 de un metro de largo) que se potencia nuestra bombilla!!!!!! Si bien cultivado su bombilla brillará para aproximadamente un mes con cero contaminación y cero electricidad!!!!!! Concedido su no muy brillante, pero usted puede ahorrar costes de electricidad si reemplazó una luz de noche, o podría utilizarlo para leer mapas o libros de camping y no preocuparse de cambiar las baterías en la linterna y deshacerse de las baterías provocando más contaminación!!!!!!
Medidor de contaminación de agua
Este instructivo también demostrará cómo brillantes bacterias puede probar cómo tóxico agua es. Los métodos utilizados son mucho más ecológicos que los productos químicos y procesamiento de... No sólo bacterias bioluminiscentes reducir la contaminación, pueden también detectar!!!!!! El proceso que brilla intensamente es consecuencia directa del metabolismo de las bacterias. Agua limpia no afecta su metabolismo celular o cómo brillante brilla. Sin embargo toxinas incluso leves que no podemos oler, ver o probar pueden alterar el metabolismo de las bacterias y reducen la cantidad de luz que pueden producir. Comparando la cantidad de luz emitido de bacterias tratadas con agua limpia para de la muestra a la mano... Decir de un arroyo cerca de una planta de energía que podemos evaluar el nivel de toxicidad en el agua!!!!!!
Aquí está un video de lo que las bacterias parecen vivos bajo alta ampliación: